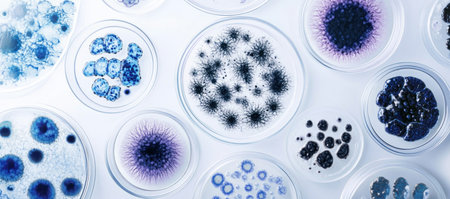
A collection of petri dishes containing different microorganisms, captured under the microscope with a white background. The petri dish on the left side contains bluish bacteria and purple moss, while those in the center feature various circular shapes including black spots or tiny cells. On the right is an entire cell within one round plate. High resolution, detailed. --ar 34:15 --v 6.1 Job ID: 03e9bae0-9bdf-41ed-bb1f-a7d4119c2929の素材

素材 - A collection of petri dishes containing different microorganisms, captured under the microscope with a white background. The petri dish on the left side contains bluish bacteria and purple moss, while those in the center feature various circular shapes including black spots or tiny cells. On the right is an entire cell within one round plate. High resolution, detailed. --ar 34:15 --v 6.1 Job ID: 03e9bae0-9bdf-41ed-bb1f-a7d4119c2929
作品情報
A collection of petri dishes containing different microorganisms, captured under the microscope with a white background. The petri dish on the left side contains bluish bacteria and purple moss, while those in the center feature various circular shapes including black spots or tiny cells. On the right is an entire cell within one round plate. High resolution, detailed. --ar 34:15 --v 6.1 Job ID: 03e9bae0-9bdf-41ed-bb1f-a7d4119c2929
- ID:260711669
- 作品種別:
- 作者名:Alfath Grafis
キーワード
- analysis
- bacteria
- biology
- black
- blue
- cells
- colony
- culture
- development
- discovery
- disease
- dish
- dots
- experiment
- fungus
- genetic
- germs
- growth
- healthcare
- infection
- innovation
- investigation
- lab
- medicine
- microbe
- microbiology
- microscopic
- mold
- molecular
- organism
- petri
- plate
- process
- purple
- research
- sample
- science
- scientific
- spot
- study
- technology
- test
- view
- virus
- white
類似作品
many empty whit...
Plates layer on...
Close-up of sta...
stacks of color...
Wooden crockery...
A congested sin...
Dirty dishes in...
Big set of empt...
washed dishes i...
A hand scrubs a...
Rustic wooden s...
A kitchen count...
Dirty sink with...
White ceramic c...
Rows of empty p...
White storage s...
Stack of white ...
drying dishes w...
Compartment Pla...
shiny restauran...
lots of dirty w...
In a minimal ki...
Antique porcela...
Many colorful c...
Kitchenware and...
Bowls were stac...
Closeup photo o...
Ceramic pottery...
Empty plate
Dinnerware
Dirty dishes an...
Pile Of Plates ...
Ceramic plates ...
A close-up shot...
Clay plates for...
Clean plates, b...
lots of dirty w...
Stacks of Clean...
Dishware and ut...
Set of Festive ...
Different table...
Top view of var...
An overhead sho...
White ceramic p...
Chaos Unleashed...
?eramic bowls o...
Dishes are neat...
Rustic kitchen ...